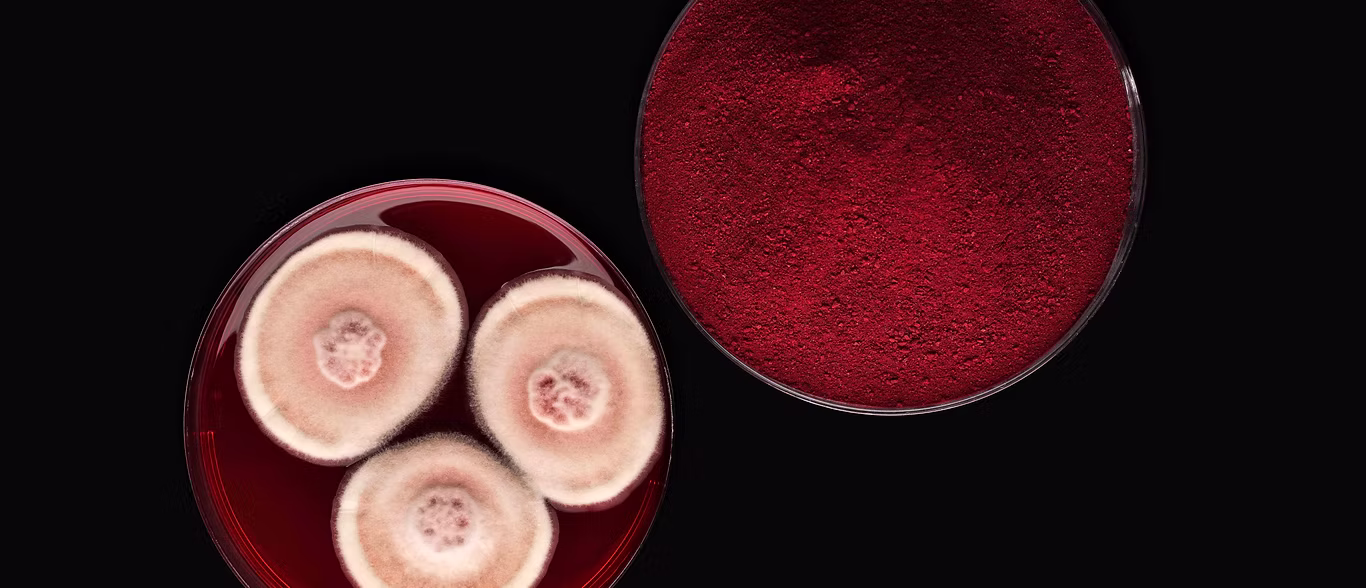
Chromologics

Danish biotech company Chromologics has secured €7 million from Novo Holdings, EIFO (the Export and Investment Fund of Denmark), Döhler Ventures, Collateral Good Ventures, and Synergetic. The raise takes the total capital secured by the company to almost €20 million, following a €12.6 million seed round in 2023.
Chromologics will use the funding to complete regulatory submissions for its natural, fermentation-derived vegan food colour, Natu.Red®, with the European Food Safety Authority (EFSA) and the US Food and Drug Administration (FDA). The capital will also support the company’s product launch and the scale-up of production in collaboration with its large-scale CMO partner, providing access to high-capacity fermentation facilities.
Natu.Red® is said to offer a high-performing, heat- and pH-stable solution based on a stable supply chain. Over the past four years, Chromologics has conducted trials with more than 90 food manufacturers across Europe and the US, gaining valuable insights into the performance and application potential of the ingredient.
The company says it is already experiencing strong customer interest across multiple applications, including plant-based products and confectionery.
“Biomanufacturing remains essential to stabilise food supply chains”
Chromologics was founded in 2017 as a spin-out from the Technical University of Denmark (DTU). The new raise comes after a commonly used colouring, synthetic Red 3, was banned in the US, increasing the demand for natural alternatives.
According to Chromologics, fermented natural colours are more sustainable than natural colours extracted from fruits and vegetables, as they require fewer resources to produce. They are also said to provide consistent quality, independent of season or geographies.
“In times of shifting priorities, we deeply value the continued trust in our mission,” said Gerit Tolborg, CEO of Chromologics. “Biomanufacturing remains essential to stabilise food supply chains – an endeavour that requires patient investors who understand the realities of innovation. The support from our existing shareholders underscores the confidence in both Chromologics’ technology and its commercial potential. Chromologics has demonstrated the cost efficiency, scalability, safety, and product-market fit of Natu.Red®.”



